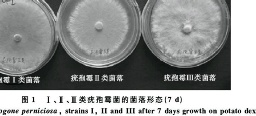

九种杀菌剂对双孢蘑菇有害疣孢霉及其菌丝的毒力测定
Toxicity of Nine Fungicides to Mycelial Growth of Agaricus bisporus and Three Mycogone perniciosa Strains
【作者】 兰清秀; 王兴全; 卢政辉;
【Author】 LAN Qingxiu1,WANG Xingquan2,LU Zhenghui1 1Edible Fungi Institute of Fujian Academy of Agricultural Sciences,Fuzhou,Fujian 350014,China; 2Well(FuJian) Co.Ltd,Lianjiang,Fujian 350500,China
【机构】 福建省农科院Manbetx体育手机版V17版本发布.官网安卓网.香港研究所; 威尔(福建)生物有限公司;
【摘要】 采用生长速率法测定9种杀菌剂对蘑菇疣孢霉属(Mycogone)3个类型菌株和双孢蘑菇(Agaricusbisporus)菌丝的室内毒力。结果表明:不同杀菌剂对不同类型疣孢霉菌株和双孢蘑菇菌丝生长均具有不同程度的抑制作用,Ⅰ、Ⅱ、Ⅲ类菌株的最佳杀菌剂分别为氟硅唑(EC50=0.0058μg/mL)、咪鲜胺(EC50=0.0067μg/mL)、戊菌唑(EC50=0.0287μg/mL),双孢蘑菇菌丝对咪鲜胺(EC50=2.2526μg/mL)敏感性最小,综合分析,氟硅唑、咪鲜胺均适用于疣孢霉Ⅰ、Ⅱ类菌的防治,百菌清(EC50=0.0631μg/mL)可用于Ⅲ类菌防治。 更多还原
Manbetx体育手机版V17版本发布.官网安卓网.香港 双孢蘑菇; 疣孢霉; 杀菌剂; 毒力测定;
【文内图片】
,if,B类沈抱.菌的菌落形态)7d)
【基金】 福建省农业科学院青年基金项目(编号:2011QC-19);国家星火计划项目专题1(编号:2011GA72008)的部分研究内容
【分类号】S436.461





